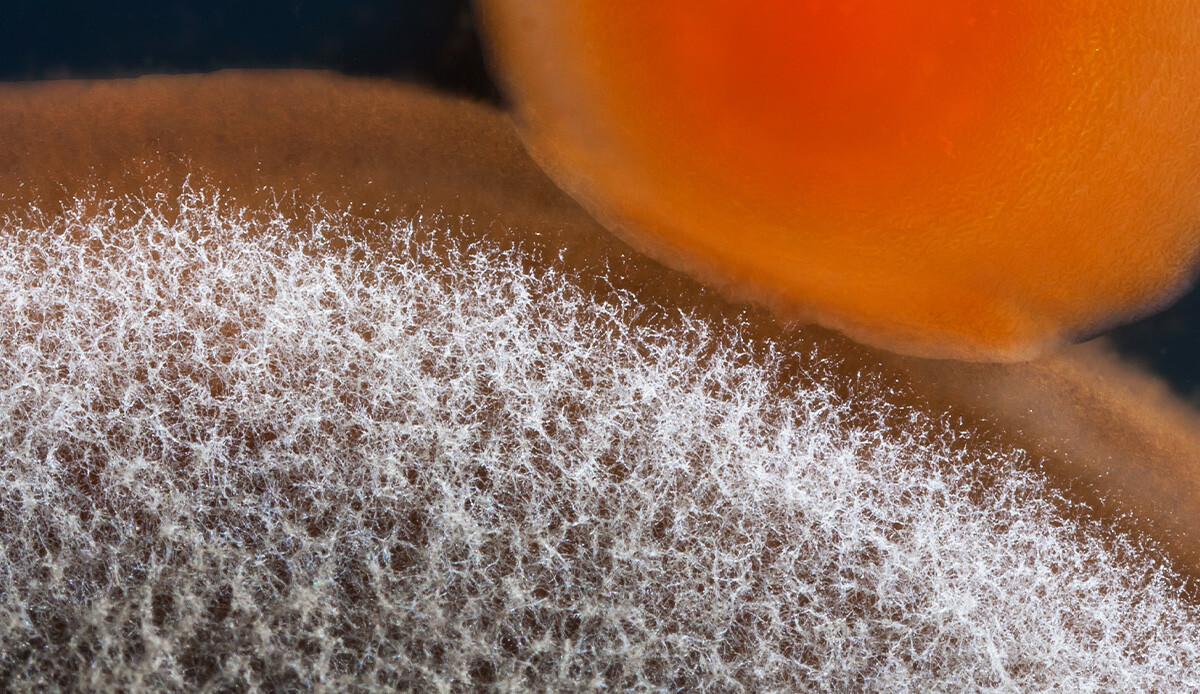

Temizlik yaparken gözden kaçan hata! Sık sık hasta olmanızın nedeni olabilir...
Temiz ve hijyenik bir yaşam alanı pek çok kişi için olmazsa olmaz. Ancak yapılan bazı hatalar, hastalıklara davetiye çıkarıyor.
Alerjik hastalıklar özellikle gelişmiş ülkelerde son yıllarda inanılmaz bir artış gösteriyor. Üstelik bunun nedeni genetik yatkınlık da değil. Evlerimizi temiz tutmak, titiz olmak sağlık için gerekli olabilir. Ancak fazlası sağlığımıza da zarar veriyor.
Uzmanlar astım ve alerji hastalarının başta olmak üzere temizlik yaparken, hijyen ürünlerinin kullanılması gerektiğini belirtiyor, havalandırma konusunda dikkatli olmaya davet ediyor.
Akşam’da yer alan habere göre; Göğüs Hastalıkları Uzmanı Prof. Dr. Cüneyt Saltürk, temizlik sırasında dikkat edilmesi gerekenleri şu sözlerle anlattı:
-Mevsimsel geçişlerde sırasında evlerde yapılan tanzim ve temizlik dönemi beraberinde yoğun şekilde temizlik aksesuarlarının ve kimyasalların kullanımını getiriyor. Özellikle de eğer evinizde bir astım hastası varsa temizliği yapan kişi kadar, yapılırken hasta olan aile bireylerinin yoğun derecede olumsuz etkilenmesi söz konusu olabilir.
-Günlük yaşamda hemen hemen her evde kullanılan bu maddeler, modern yaşamın ayrılmaz bir parçası olmuştur; ancak tozların, lekelerin uzaklaştırılması veya dezenfeksiyon amacıyla kullanılması, maddelerin solunması hava yolu hassasiyetini-reaksiyonunu artırmakta.
İÇERİĞİNE DİKKAT EDİN
-Daha önce sağlık geçmişinde alerjik hastalığı ve astım tanısı olan kişiler başta olmak üzere herkesin, temizlik yaparken tercih ettiği ürünlerin içeriğindeki kimyasal maddeleri mutlaka incelemeleri, bu kimyasal maddelerin onaylı ve resmi makamlarca onaylanmış ürün olmasına dikkat etmeleri çok önemli.
-Merdiven altı olan veya markası alınan kimyasal maddeleri kullanmaktan, sadece astım hastaları değil hepimiz uzak durmalıyız. Temizlik sırasında doğru şekilde havalandırma yapılması da hayati önemde.